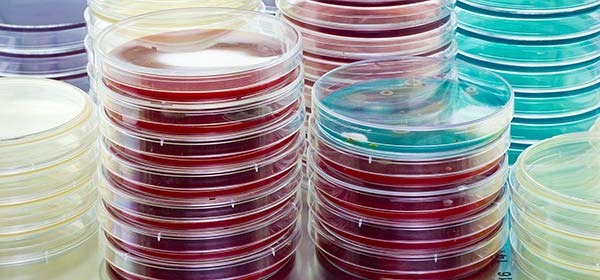
Petri dishes in the microbiology lab at Hohenstein Medical

Safe use and reuse of medical devices depend on validated cleaning, disinfection and sterilization procedures. Hohenstein supports manufacturers in verifying that these processes consistently achieve the required level of cleanliness and microbiological safety.
Our testing and documentation align with ISO 17664, DIN/TS 5343 and ISO 14971, ensuring global regulatory compliance while supporting FDA submissions.
Validation & Process Review
We review the manufacturer’s Instructions for Use (IFU) and perform cleaning validation according to ISO 17664-1 for critical and semi-critical devices or ISO 17664-2 for non-critical devices. Each validation includes:
- Assessment of the manufacturer’s processing instructions
- Risk analysis according to ISO 14971
- Definition of acceptance criteria for cleanliness
- Selection and validation of suitable test procedures
Verification Testing
After processing, all acceptance criteria must be met. Hohenstein performs targeted analyses to confirm effectiveness, including:
- Bioburden testing (ISO 11737-1)
- Endotoxin testing (LAL) (AAMI ST72, ISO 11737-3)
- Residue analysis (TOC, THC)
- Protein detection (BCA method)
- Particulate measurement
- Cytotoxicity testing (ISO 10993-5)
- Material change evaluation (chemical characterization per ISO 10993-18)
Reusable Device Reprocessing & End-of-Life Simulation
We evaluate reprocessing procedures (the cleaning, disinfection and sterilization of reusable medical devices) to verify that they maintain safety and performance over time. We simulate repeated reprocessing cycles using standardized or customer-specific methods, such as thermal, chemothermal or chemical disinfection followed by steam sterilization.
These simulations assess device cleanliness, functionality and biocompatibility throughout the validated service life to ensure continued compliance and patient safety.
Residue Detection & Surface Cleanliness
Residue testing confirms that cleaning agents and process aids are effectively removed.
- TOC (Total Organic Carbon) quantifies water-soluble organic residues
- THC (Total Hydrocarbon) measures water-insoluble contaminants containing hydrocarbons
These analyses verify that surfaces meet cleanliness specifications and that no residues remain that could compromise safety or device function.